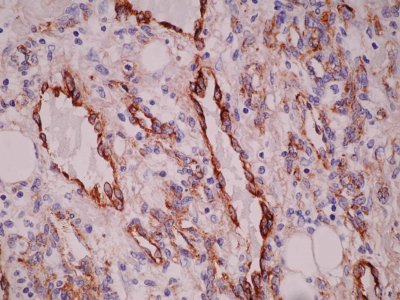

Breast Angiosarcoma
C Lilaia, F Pereira, S André, B Cabrita
Keywords
angiosarcoma, benign phyllodes tumor, breast cancer, positron emission tomography, total mastectomy
Citation
C Lilaia, F Pereira, S André, B Cabrita. Breast Angiosarcoma. The Internet Journal of Gynecology and Obstetrics. 2006 Volume 6 Number 2.
Abstract
Angiosarcoma of the breast is a rare entity and it has the worst prognosis of all breast malignancies. It is a highly aggressive tumor and the total mastectomy is the preferred treatment. The development is distinguished by general metastasis. It has a tendency to affect young women. Histologically, the angiosarcomas are divided into well and poorly differentiated categories. The survival is closely related to the histologic grade. This case of breast angiosarcoma emphasizes the difficulties in the clinical diagnosis.
Introduction
Angiosarcoma of the breast is a rare entity and it has the worst prognosis of all breast malignancies1. It is a highly aggressive tumor and the total mastectomy is the preferred treatment2. The development is distinguished by general metastasis1.
The typical presentation is a mass with bluish discoloration of the overlying skin, usually greater than 2 cm in size and locally infiltrative, with ill-defined borders. It has a tendency to affect young women with a mean age of 34 years3.
Although radiation therapy-naive angiosarcomas tend to occur in younger patients, they behave similarly to radiation therapy-associated angiosarcomas4.
Histologically, the angiosarcomas are divided into well and poorly differentiated categories. In well-differentiated angiosarcoma, the endothelial cells form freely anastomosing, irregular vascular channels, which are lined by flat endothelial cells having enlarged hyperchromatic nuclei and occasional mitotic figures. Sometimes villous papillary formation occurs. Ill-defined borders and local infiltration are essential features. In biopsies, these characters may be absent making correct diagnosis difficult. In the poorly differentiated angiosarcoma the malignant nature is apparent with anaplastic endothelial cells forming complex vascular channels or solid sheets. The latter case often suggests a poorly differentiated carcinoma. A correct diagnosis requires immunohistochemical stain for Factor VIII or endothelial cell markers2.
The survival is closely related to the histologic grade. The five-year disease free survivor rate is 76% for low grade, well differentiated tumors and 70% for intermediate grade and 15% for high grade, poorly differentiated neoplasms3.
Case report
A 29 year old healthy female discovered a painful right breast mass by self-examination. The mass, located on upper external quadrant of the right breast, was oval in shape and measured about 3 centimeters of diameter. The pain had no relation with the menstrual cycle phase and was often persistent. She did not notice any discoloration of the overlying skin. A mammary ultrasound was made then and no such mass was identified.
In her gynecological history, our patient had menarche at 14 years old with regular menstrual cycles of 28 days cycle and 5 days duration. Regarding her obstetric history, she had two ectopic tubal pregnancies and she underwent salpingectomy twice (at 22 and 25 years old).
As the symptomatology persisted, she repeated the ultrasound about six months later. On ultrasonography, a hypoechoic oval mass with an ill defined though hyperechoic boundary, 6 mm x 15 mm in diameter was detected. She underwent fine needle aspiration biopsy and cytology which revealed benign phyllodes tumor. She was then referred to the Senology unit.
On mammary exam she had an oval nodule, located on upper external quadrant of the right breast, 7 centimeters of diameter, smooth and elastic in consistency, and bosselated contours. She did not have any suspicious axilla lymphadenopathy. Tumorectomy was then decided. Intraoperatively, the tumor had an ill-defined boundary, which made the complete excision difficult. Surprisingly the anatomical-pathological diagnosis was of breast angiosarcoma, poorly differentiated type.
Unfortunately she was away from the country for nearly 4 months and did not come for the scheduled appointments. On mammary exam a tumor recurrence was noticed then. A magnetic resonance imaging was performed before surgery. The tumor had heterogeneous signal intensity on T1 and T2 weighted images. MRI with Gd- DTPA images showed higher and heterogeneous signal intensity, suggestive of an atypical lesion. She underwent total mastectomy. There were no complications in the post-operative period.
Concerning follow-up, she underwent positron emission tomography, which was negative and thoracic computerized axial tomography, which did not show any pulmonary metastases. Six months after the mastectomy she was free of recurrence and metastasis.
Figure 1
Figure 2
Figure 3
Figure 4
Figure 5
Figure 6
Discussion
This is a case report of a rare breast cancer in a radiation therapy-naive young patient, which emphasizes the difficulties in the clinical diagnosis of this entity5. Fortunately six months after total mastectomy our patient was free of local recurrence and distant metastases. She would require close followup for recurrence.